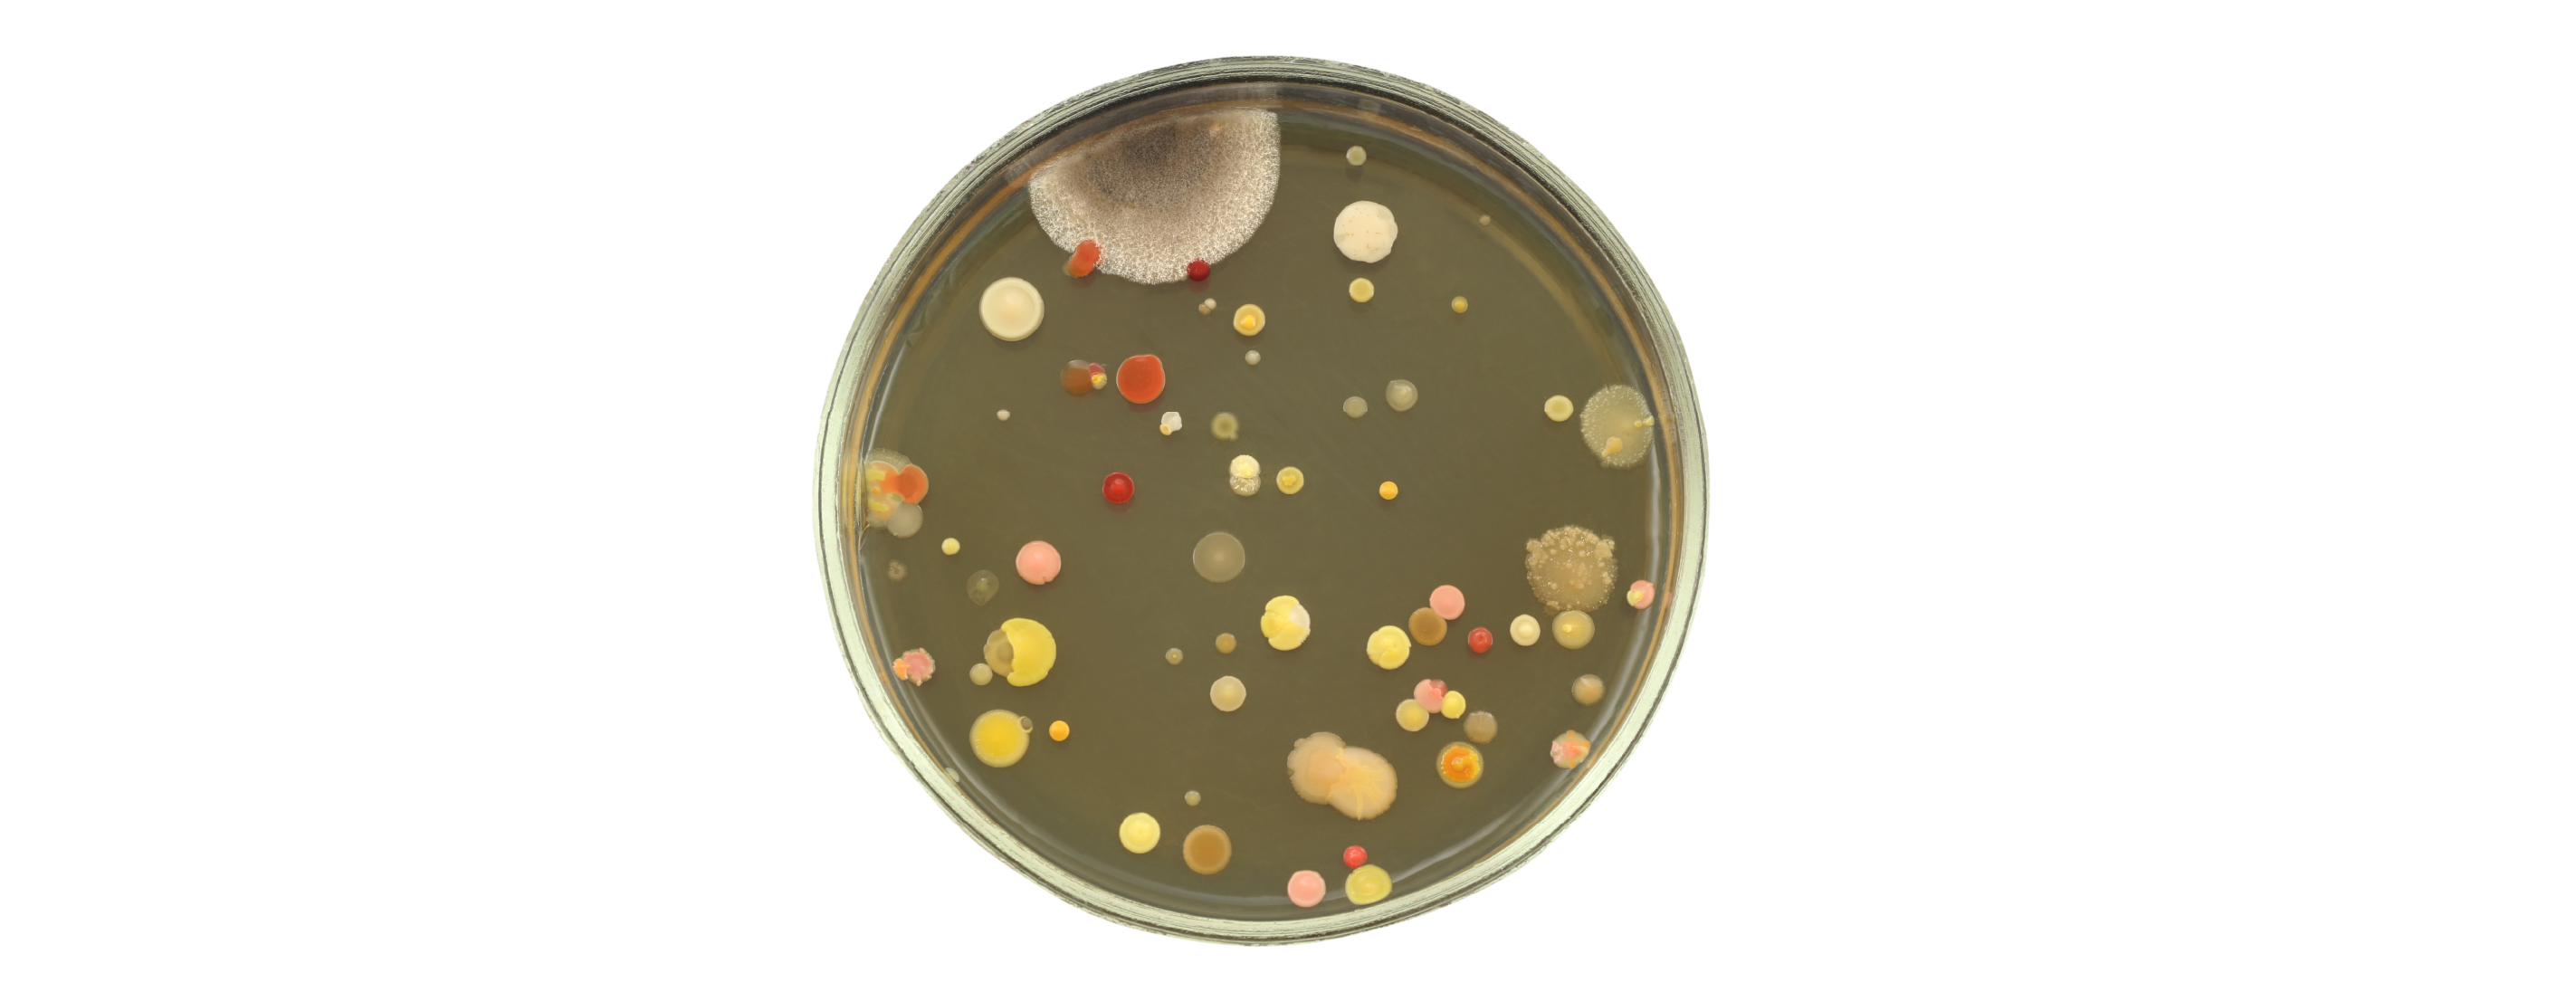
How Do I Control Moisture Contamination in my Compressed Air Supply?

Key features
- Measurement ranges -110 up to +20°Cdp
- Dew point or ppmV moisture content output
- Accuracy ±2 °Cdp
- Traceable calibration certificate
- Easidew I.S. IECEx, cQPSus, ATEX and UKCA approvals
- Low cost of ownership and easy maintenance with sensor exchange program
- 316 Stainless steel sensor and sample blocks
- 5/8” UNF, 3/4” UNF, G 1/2” process connections
- MiniDIN 43650, M12 electrical connectors
- Oxygen Service cleaned Associated Oxygen Sensor
Industry 4.0 Data Monitoring System
Overview
The Easidew sensor is a moisture meter that measures both dew point and moisture content. It is simple to install as it is available with a wide range of process connections and electrical connectors. All Easidew dew-point transmitters are available with a service exchange program which reduces the cost and time spent on maintenance.
Reconfiguration of the transmitters is simple with the self-contained Easidew and Pura communications kit.
Michell’s Ceramic Metal-Oxide Moisture Sensor-based Hygrometers are calibrated to international standards and are delivered with a traceable calibration certificate...
Resources
Datasheets
Order Codes
Brochures
Manuals
Certificates
Canadian Registration Number
Electrical Safety
Pattern Approval (Metrological)
Software
Declarations
CAD/STEP/Diagrams
Accreditation & Compliance 7 items ]
Suitable Applications
- Compressed air Class 1 to Class 6 dryers
- Breathing air quality and safety
- Moisture in Hydrogen cooled electricity generators
- Quality of inert and bulk gases
- Monitoring controlled conditions in glove boxes
- Quality of welding gases
- Moisture and dew-point measurements in hazardous areas
- Oxygen purity applications
Learn More About Selected Applications
-
1) What is the difference between polymer and ceramic metal-oxide sensors?
Both are capacitance sensors but utilize different materials. The polymer sensor has a faster response and operates best at dew points >-50 °C. The ceramic metal-oxide sensors can respond down to -120 °C dew point and can operate in a larger range of background gases.
-
2) Do the sensors need to be calibrated?
Yes, the sensors should be calibrated on a regular basis to ensure consistent quality and operational efficiency. An alternative option is our sensor exchange program. A newly calibrated, refurbished transmitter is swapped with your existing one, which is then shipped back to our factory. The advantage of this is that there is no measurement downtime compared to shipping sensors off for recalibration.
-
3) What do the different color sensor caps mean?
To help identification of the process connection on shipped sensors, the sensor cover color corresponds to the type of thread of the process connection:
Black G 1/2" BSP Green 3/4" UNF Blue 5/8" UNF -
4) Can I replace the sensor without disrupting the production process?
Yes. With the sensor exchange program, downtime during replacements is avoided.
-
5) What is the ideal application for a dew-point transmitter?
Dew-point transmitters are used in many compressed gas treatment and contained environment applications, to monitor moisture contamination.
-
6) Can the transmitters be used in a hazardous area?
The Easidew I.S. and the Easidew PRO I.S. are intrinsically safe so, once installed with an electrical barrier, can be used in hazardous areas.